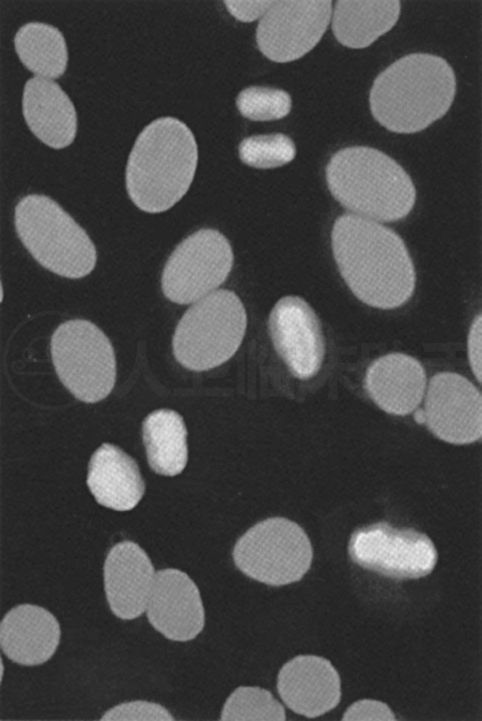
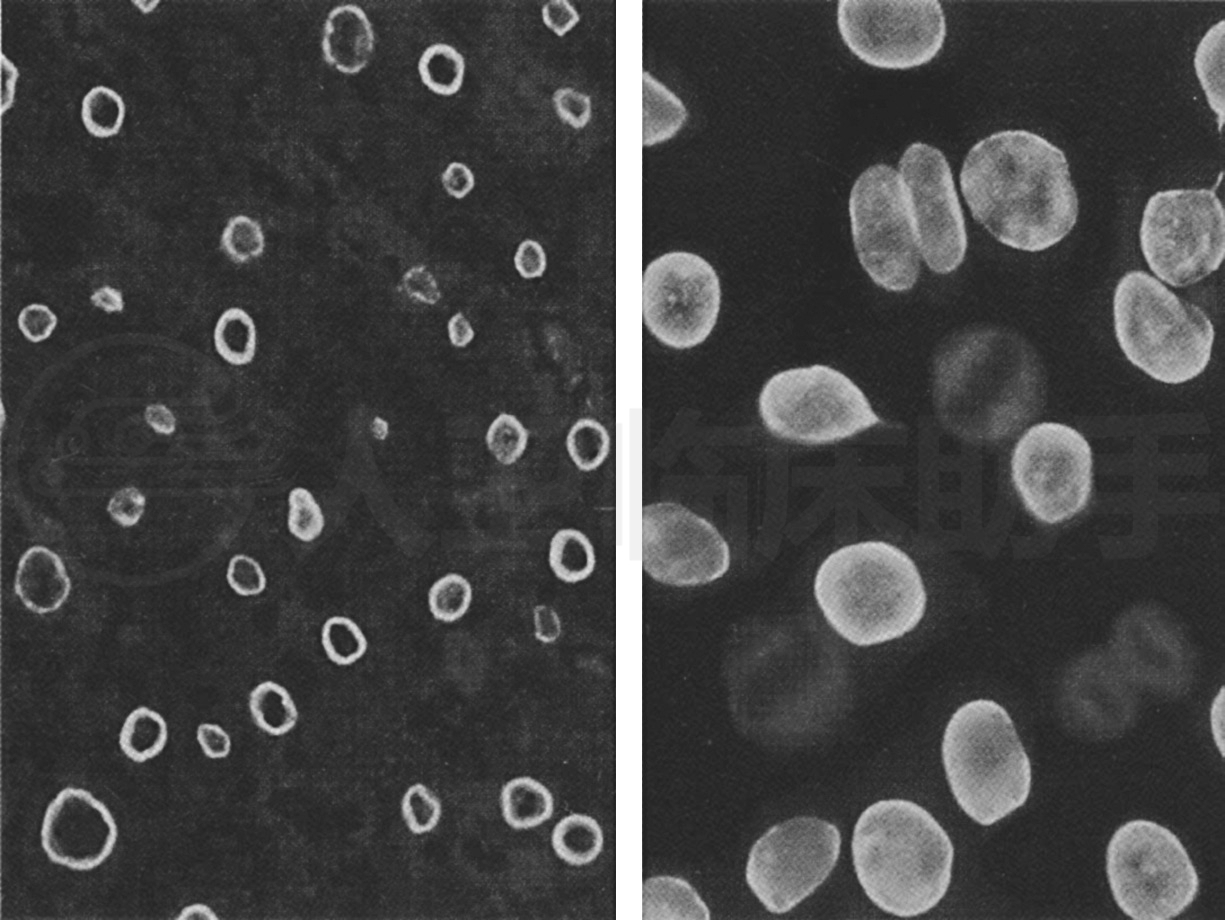
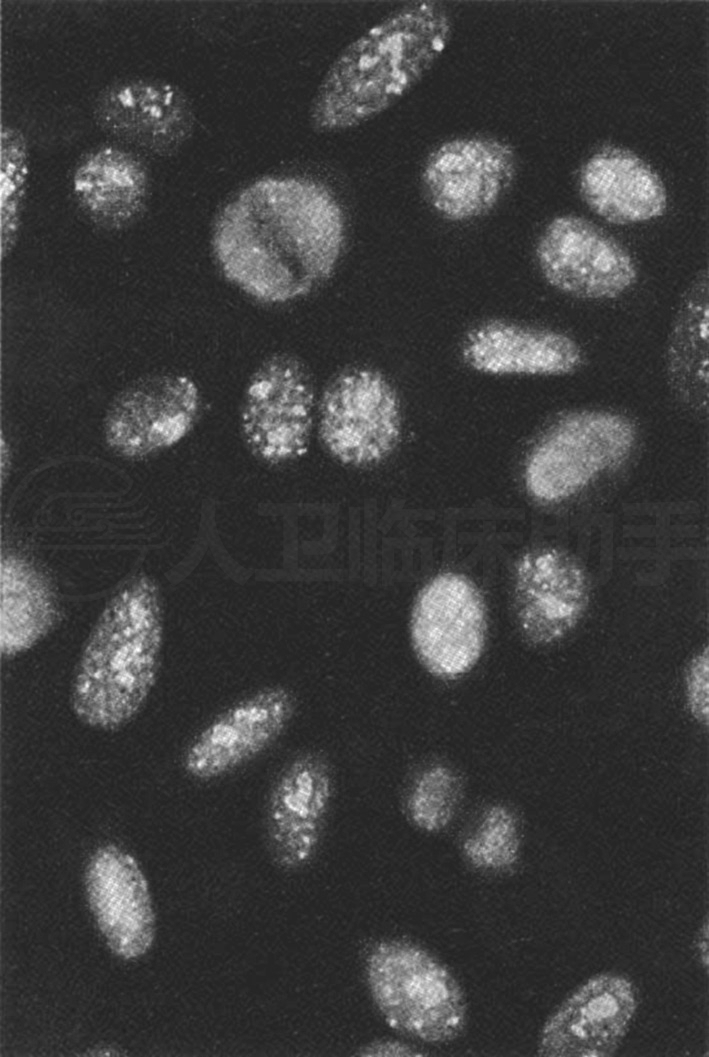

中文名称 :抗核抗体检测试验
英文名称 :
别 名 :
ICD 号 :c16.9
抗核抗体(antinuclear antibody,ANA)是指抗细胞核抗原成分的自身抗体的总称,现广义的概念是指一组抗真核细胞内所有抗原成分自身抗体的总称(包括抗核酸和核蛋白所有细胞成分抗体的总称)。抗核抗体主要是指IgG,也有IgM、IgA、IgD和IgE,其可与不同来源的细胞核成分起反应,无器官和种属特异性。ANA主要存在于血液中,也可存在于胸水、关节滑膜液等体液中。临床上通常采用荧光素标记的间接免疫荧光法进行检测,目前最常用的是核质丰富的培养细胞——HEp-2细胞作为抗原。当患者血清中ANA与核抗原结合,形成抗原-抗体复合物,此时再加入荧光素标记的抗人IgG抗体,反应后,标记抗人IgG再与免疫复合物结合,在荧光显微镜下可观察到抗原片上ANA荧光强度和模型。
间接免疫荧光法检测ANA可出现20多种荧光模型,其代表不同种类的自身抗体,常见的ANA荧光模型及临床意义如下。
细胞核均匀着染,有些核仁部位不着色,分裂期细胞染色体部位着染(图14-1)。与均质型相关的自身抗体主要有抗组蛋白抗体、抗dsDNA抗体及抗核小体抗体等。高滴度均质型主要见于SLE患者,低滴度均质型可见于RA、慢性肝脏疾病、传染性单核细胞增多症或药物诱发的狼疮患者。
又称核颗粒型或斑点型,细胞核内出现颗粒状荧光,分裂期细胞染色体无荧光显色(图14-2)。与颗粒型相关的自身抗体涉及抗核糖体核蛋白颗粒抗体,如抗Sm、抗U1RNP、抗SSB等抗体。高滴度的颗粒型常见于混合性结缔组织病,同时也见于SLE、硬皮病、SS等自身免疫性疾病。
Fig. 14-1 Typical diagram of homogeneous antinuclear antibodies

Fig. 14-2 Typical diagram of speckled antinuclear antibodies
荧光着色主要显示在细胞核的周边形成荧光环,或在均一的荧光背景上核周边荧光增强(图14-3)。相关抗体主要是抗板层素抗体、抗gp210抗体等。高滴度的周边型与自身免疫性肝病有关,且提示病情活动。
Fig. 14-3 Typical diagram of membranous antinuclear antibodies
荧光着色主要在核仁区,分裂期细胞染色体无荧光着色(图14-4)。相关抗体是抗核仁特异的低分子量RNA、抗RNA聚合酶-1、抗U3RNP、抗PM-Scl。核仁型在硬皮病的阳性率最高,也见于雷诺现象,偶尔也出现于SLE。
Fig. 14-4 Typical diagram of nucleolar antinuclear antibodies
ANA的荧光模型分析对自身免疫性疾病的鉴别诊断具有提示作用,但要明确具体的自身抗体亚类,必须做ANA谱系分析检测,不能仅凭荧光模型做出相关自身抗体的判断。由于细胞核成分的复杂性,针对抗原性特征可产生多种类型的ANA。针对某一特定核成分的特定抗体,只在某一疾病中出现,是诊断该疾病的血清标志性抗体。各种ANA在不同的自身免疫性疾病中出现不同组合,可形成各种疾病的特征性抗体谱。ANA与常见自身免疫性疾病的阳性率见表14-4。
Tab. 14-4 Positive rate of ANA in common autoimmune diseases












